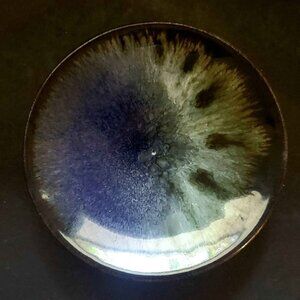

Vintage Ceramic Oil or Perfume Bottle with Saucer Made in France
$25 $90
Size
Like and save for later
Add To Bundle
Vintage Ceramic Oil or Perfume Bottle with Saucer Made in France. In perfect condition with no scratches, chips, or cracks.
This vintage ceramic oil or perfume bottle with saucer, handmade in France, is a unique and charming collectible piece. With its exquisite craftsmanship and French origin, this item adds an elegant touch to any vanity or display. Perfect for storing oils or perfumes, this set is a timeless treasure for collectors or those who appreciate fine craftsmanship.
Shipping/Discount
Trending Now
Find Similar Listings
Account is under Review
Comment posting is temporarily restricted. Our team will reach out to you shortly. To understand why, select
Learn More.